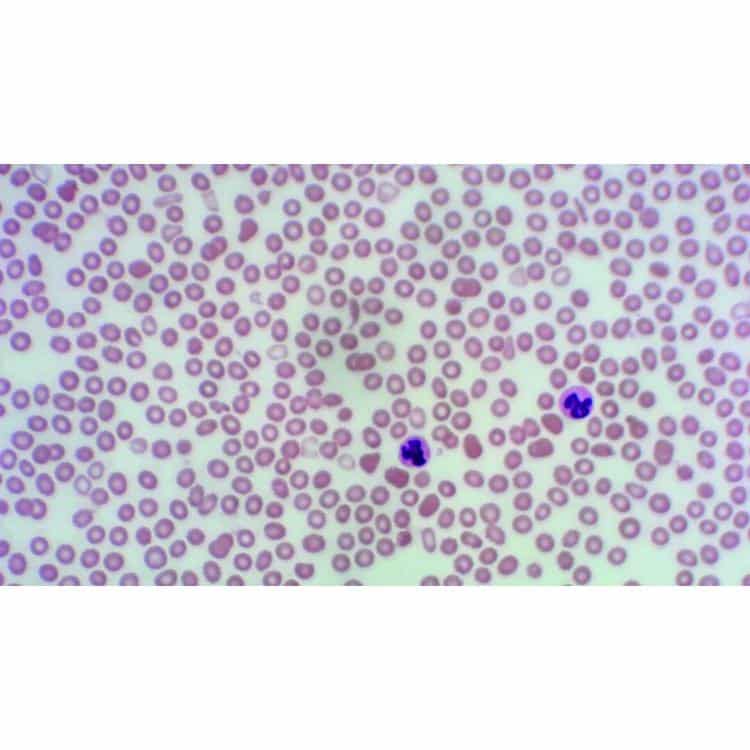

Præparat: Endokrine celler - Naturlig hyposekretorisk bovin skjoldbruskkirtel
69,00 kr. (86,25 kr. m/moms)
Præparat: Opskæring af ungt pattedyr - Blod med malaria
139,00 kr. (173,75 kr. m/moms)
Præparat: Opskæring af ungt pattedyr – Menneskeblod (giemsa)
59,00 kr. (73,75 kr. m/moms)